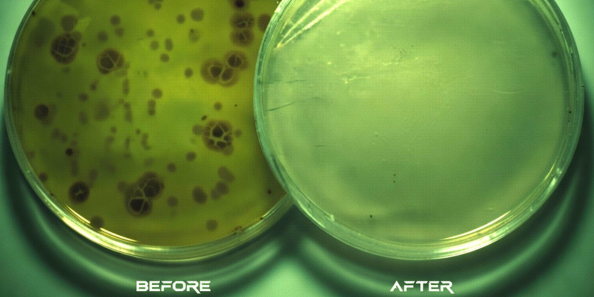
Anti-Microbial Fogging 3 EPA-registered fogging treatment for virus and bacteria control

Anti-microbial Fogging Starting at 15¢ Per Square Foot
Anti-microbial fogging price is based on building type, total square footage, and recurrence of service.
Space City Sanitizers was the first company to pioneer antimicrobial fogging in Houston during the pandemic, killing COVID contamination in hundreds of clients’ homes and businesses.
Hospital-Grade Disease Treatment
We apply a hospital grade, EPA registered sanitizing agent that eliminates all disease causing micro-organisms. Anti-microbial fogging is one of the most effective ways to keep your team, customers, and family protected from potential illness.
Safe & Eco-Friendly

Our anti-microbial fogging is safe for all indoor and outdoor application scenarios and is not harmful to humans or animals. The treated space will be ready for occupancy just minutes after the application.
EPA Certified Process

Our anti-microbial fogging is certified by the EPA for sanitizing in health care facilities as well as commercial and non-commercial spaces. We follow strict EPA guidelines for application to ensure compliance and product efficacy.
Affordable Sanitization

Our quotes are always free and we offer discounts for recurring service to your business or residence. Pricing begins at only 15 cents per square foot!
Commercial & Residential Anti-microbial Fogging
Commercial Treatment
Residential Treatment for Anti-microbial Fogging
Our Product
What type of space do you need serviced?
Our services are available in a wide variety of spaces, including offices, warehouses, schools and colleges, churches, homes and apartments, Airbnbs, hotels, restaurants, kitchens, recreation facilities, conference spaces, wedding venues, libraries, retail stores, shopping malls, grocery stores, entertainment venues, gyms and workout studios, arenas, buses, boats, airplanes, casinos, and many more.
Anti-microbial fogging benefits
- Decontaminate Interior Spaces
- Improve Air Quality
- Satisfy Sanitization Concerns
- Maintain Safety Reputation
We procedurally remove harmful pathgens from the environment using professionally-developed techniques.
Our technicians provide all of the state-of-the-art equipment required to do the job.
Air sanitization and purification devices are used within the space to eliminate odors and remnant contaminants.
Continue on with peace of mind that the location is clean and safe to use. Interior spaces are ready to use within 15 minutes.
We’re standing by for any Emergency Fogging needs and well equipped to handle jobs of any size.
Ensure that others know that you take safety seriously. Taking precautions reduces risk and liability.

Wanna know more?
Our Anti-Microbial Fogging (AKA “Space Shield”) has an antimicrobial topcoat engineered to inhibit the growth of microbes. The “active ingredient” in the coating is ionized silver in a zeolite carrier that starts neutralizing bacteria, mold, mildew, viruses on contact, and disease treatment. The technology built into the coating allows it to permanently retain its “bio-availability” for a relatively long period of time, meaning that it will continue to protect high-touch surfaces for up to 12 months depending on use.

